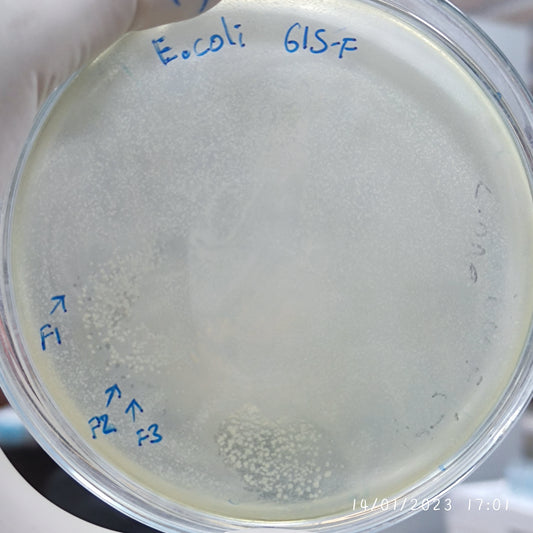
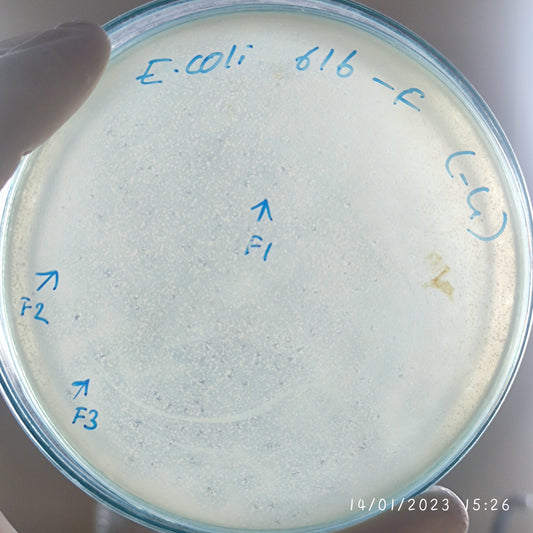
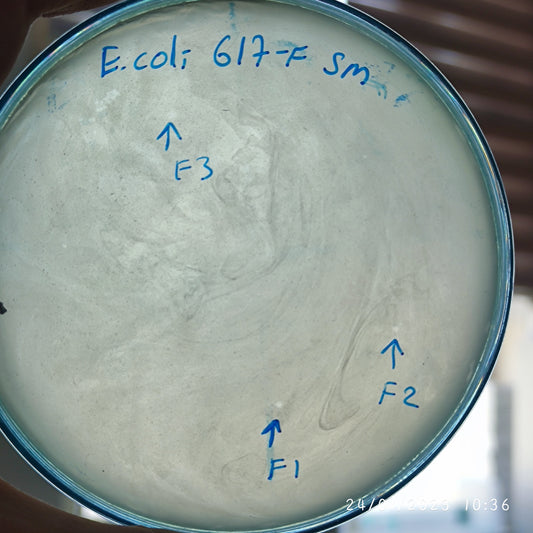
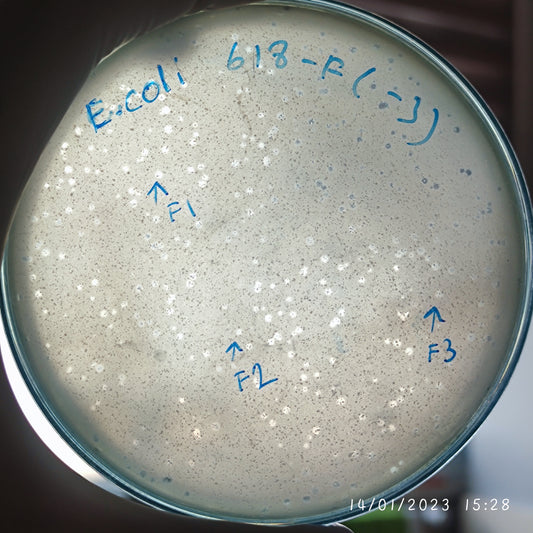
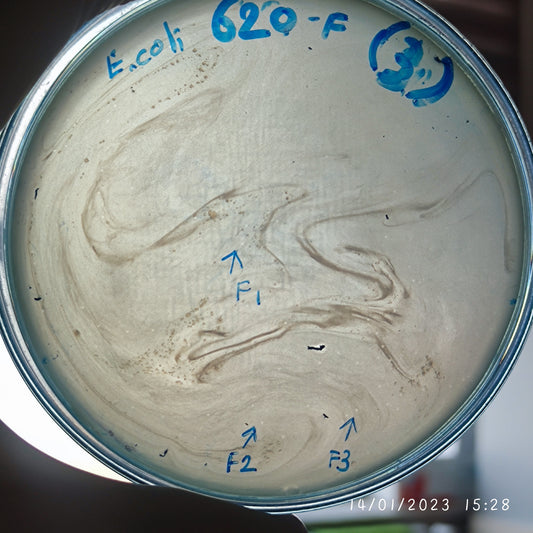
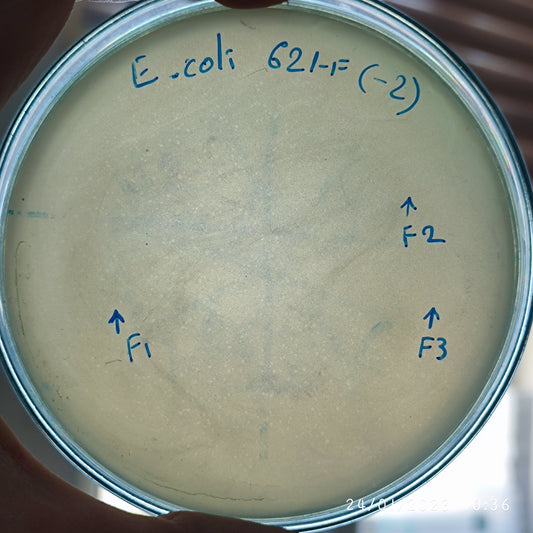
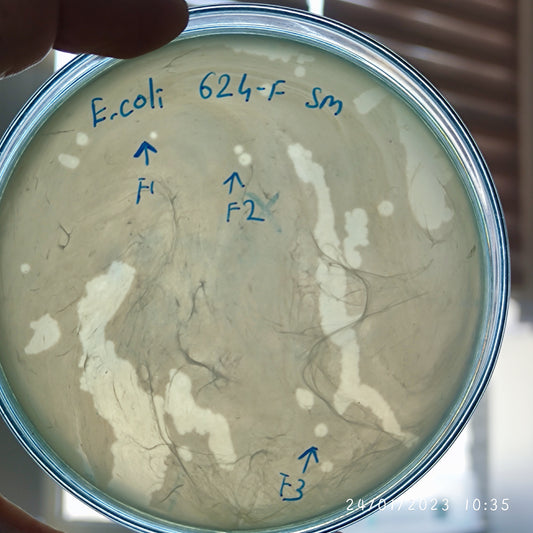
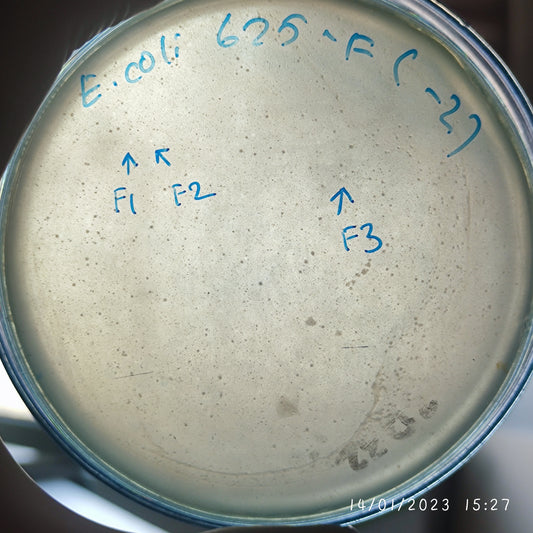
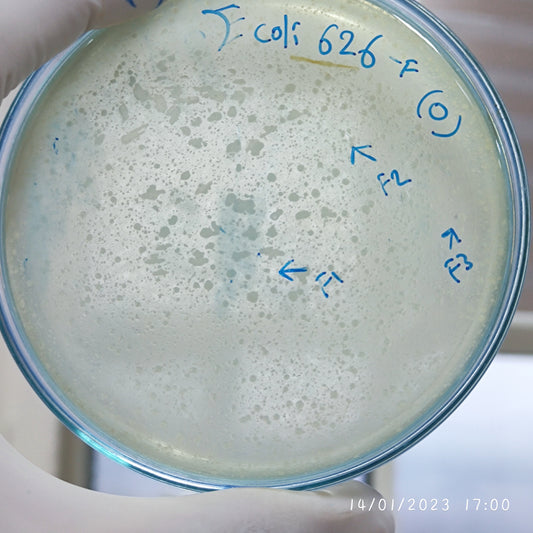
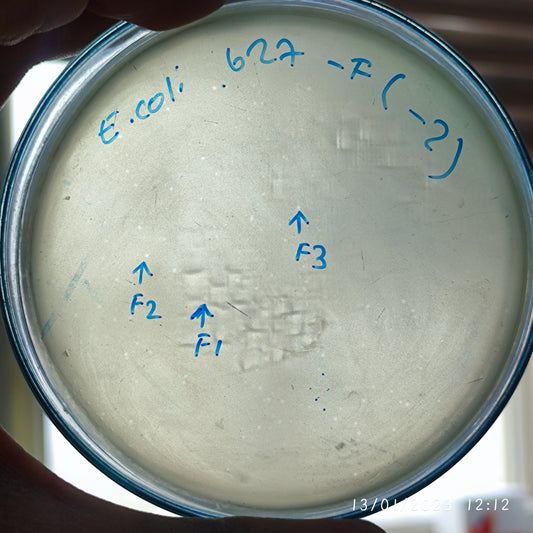
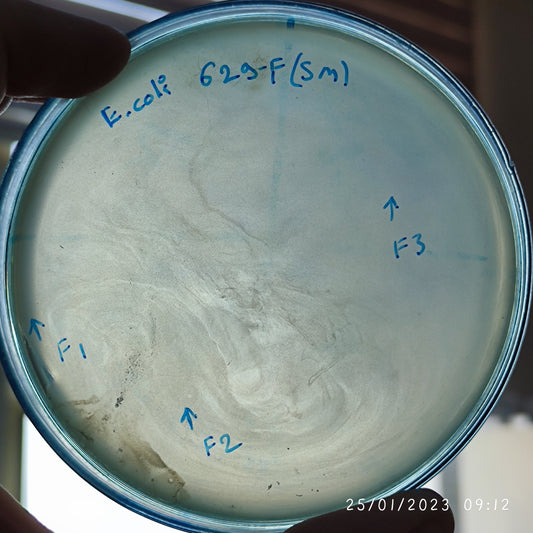
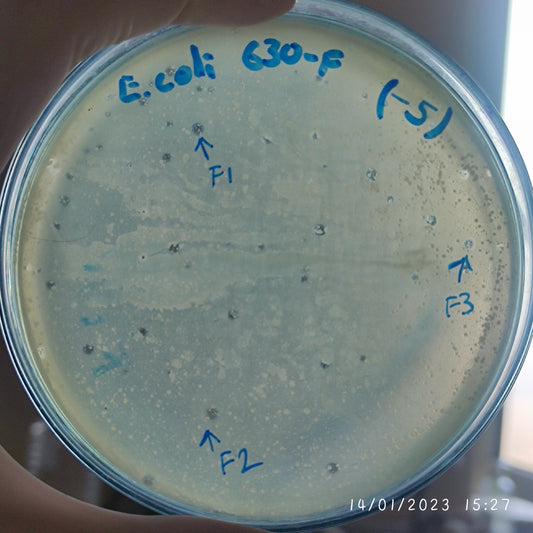
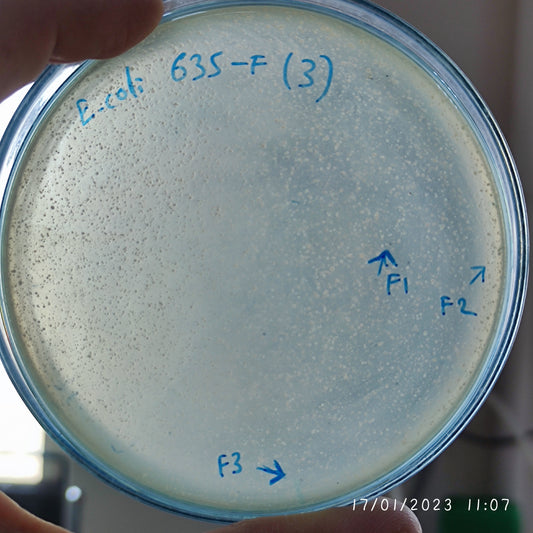
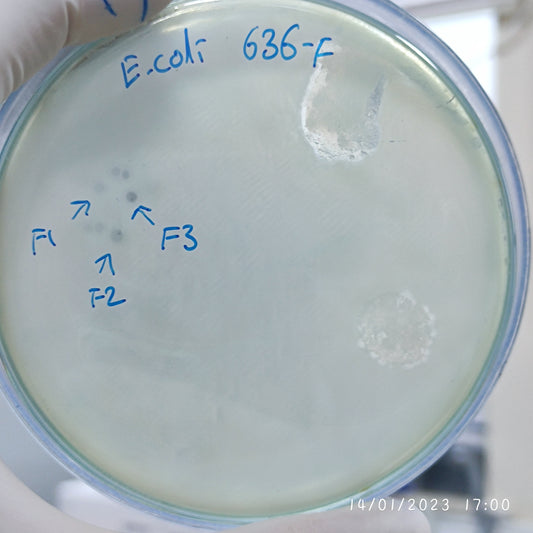

-
Escherichia coli bacteriophage 100615F
Regular price $500.00 USDRegular priceUnit price per -
Escherichia coli bacteriophage 100616F
Regular price $500.00 USDRegular priceUnit price per -
Escherichia coli bacteriophage 100617F
Regular price $600.00 USDRegular priceUnit price per -
Escherichia coli bacteriophage 100618F
Regular price $500.00 USDRegular priceUnit price per -
Escherichia coli bacteriophage 100620F
Regular price $500.00 USDRegular priceUnit price per -
Escherichia coli bacteriophage 100621F
Regular price $500.00 USDRegular priceUnit price per -
Escherichia coli bacteriophage 100624F
Regular price $750.00 USDRegular priceUnit price per -
Escherichia coli bacteriophage 100625F
Regular price $500.00 USDRegular priceUnit price per -
Escherichia coli bacteriophage 100626F
Regular price $400.00 USDRegular priceUnit price per -
Escherichia coli bacteriophage 100627F
Regular price $500.00 USDRegular priceUnit price per -
Escherichia coli bacteriophage 100629F
Regular price $650.00 USDRegular priceUnit price per -
Escherichia coli bacteriophage 100630F
Regular price $500.00 USDRegular priceUnit price per -
Escherichia coli bacteriophage 100631F
Regular price $750.00 USDRegular priceUnit price per -
Escherichia coli bacteriophage 100631G
Regular price $500.00 USDRegular priceUnit price per -
Escherichia coli bacteriophage 100635F
Regular price $500.00 USDRegular priceUnit price per -
Escherichia coli bacteriophage 100636F
Regular price $500.00 USDRegular priceUnit price per